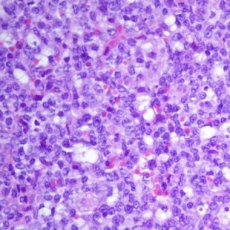

Medicina
El consumo de alcohol y los factores genéticos empeoran la miocardiopatía dilatada
Científicos del Centro de Investigación Biomédica en Red de Enfermedades Cardiovasculares (CIBERCV), en colaboración con otros centros españoles y con el Hospital Royal Brompton de Londres, han realizado un estudio en el que identifican, por primera vez, factores genéticos que predisponen en pacientes con miocardiopatía dilatada (MCD) asociada al excesivo consumo de alcohol.
En una investigación publicada en Journal of the American College of Cardiology, los expertos reportan que el efecto combinado del exceso del consumo de alcohol y contar con un condicionante genético provoca una expresión peor de la enfermedad que si se cuenta con ambos factores por separado.
(adsbygoogle = window.adsbygoogle || []).push({});
La miocardiopatía dilatada es la causa más frecuente de insuficiencia cardíaca en jóvenes y es la primera causa de trasplante cardíaco en el mundo.
Hasta ahora se conocía que en algunos casos la MCD podía deberse al consumo excesivo de alcohol pero se desconocía en gran medida qué factores determinaban la toxicidad cardíaca en la exposición al alcohol.
En este trabajo se evaluó la presencia de variantes en genes asociados en la fisiología de la enfermedad y examinaron los efectos de la ingesta de alcohol y el genotipo sobre la severidad de la miocardiopatía dilatada.
Según explica Almudena Amor, primera autora del trabajo, “en este estudio constatamos que un grupo relevante de pacientes con MCD atribuida al consumo excesivo de alcohol contaba con alteraciones genéticas y por lo tanto, se benefician de la realización de un estudio genético a ellos y sus familiares, hasta ahora no ofrecido porque se creía que su enfermedad tenía su origen en el alcoholismo”.
![[Img #50999]](upload/img/periodico/img_50999.jpg)
Pablo García-Pavía y Almudena Amor con otros de los integrantes del grupo de Cardiopatías Familiares del Hospital Puerta de Hierro. (Foto: CIBERCV)
Asimismo, este estudio reporta por primera vez que la miocardiopatía dilatada asociada a tóxicos tiene un componente de susceptibilidad genética. “Esto es muy relevante porque abre la puerta a otras cardiopatías de origen tóxico como las inducidas por algunos fármacos o drogas recreacionales”, indica el jefe de grupo del CIBERCV y coordinador del trabajo Pablo García-Pavía.
Los datos presentados en el estudio indican que los pacientes con miocardiopatía relacionada con el alcohol deberían someterse a un estudio genético para poder identificar, de esta manera, a los familiares con riesgo a desarrollar la enfermedad. (Fuente: CIBER)